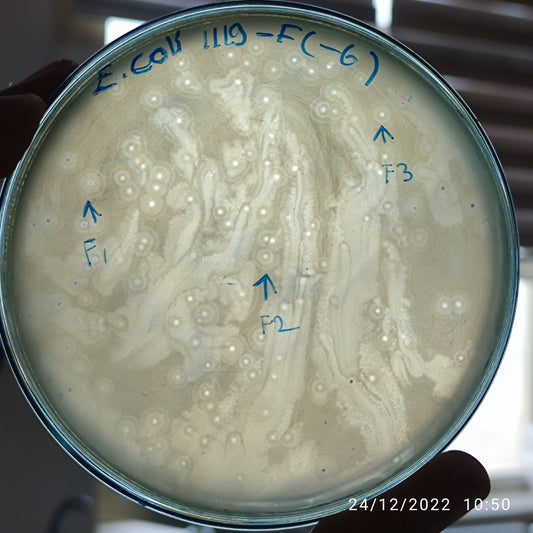
Escherichia coli bacteriophage 101119F
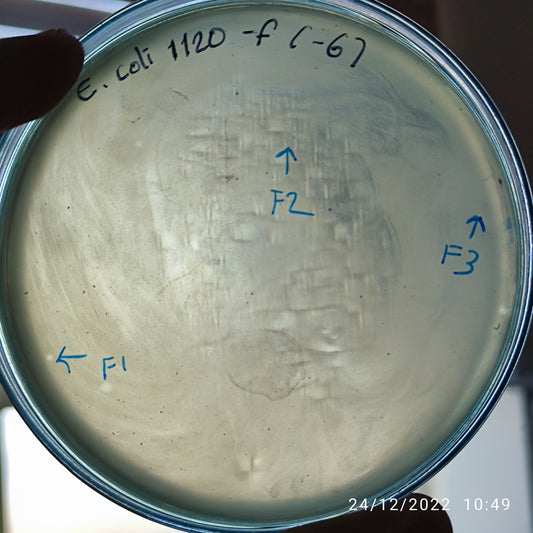
Escherichia coli bacteriophage 101120F
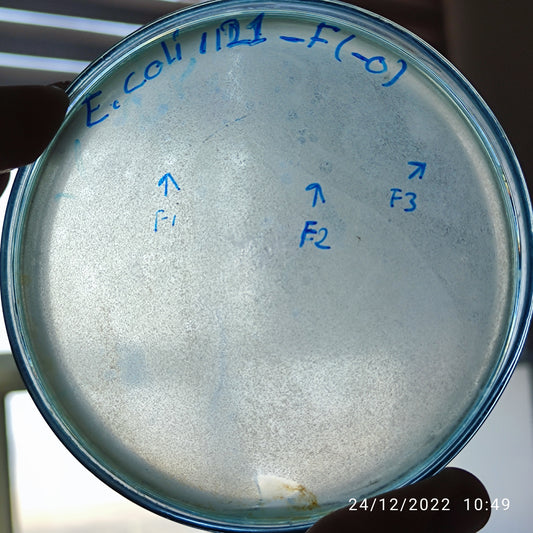
Escherichia coli bacteriophage 101121F
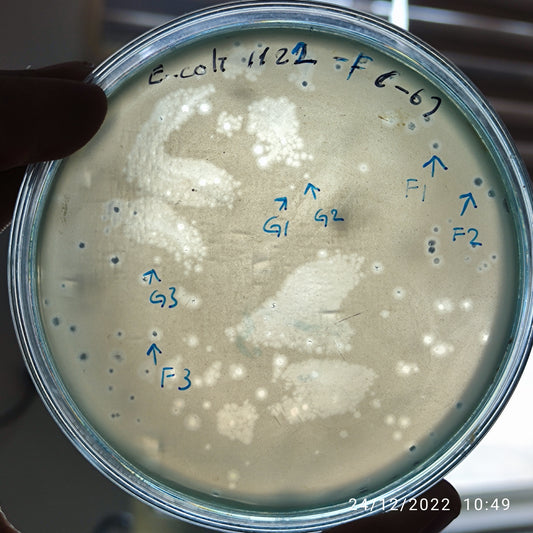
Escherichia coli bacteriophage 101122G
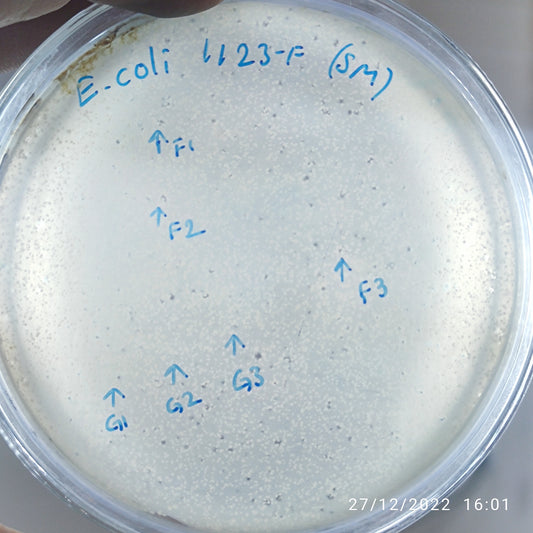
Escherichia coli bacteriophage 101123G
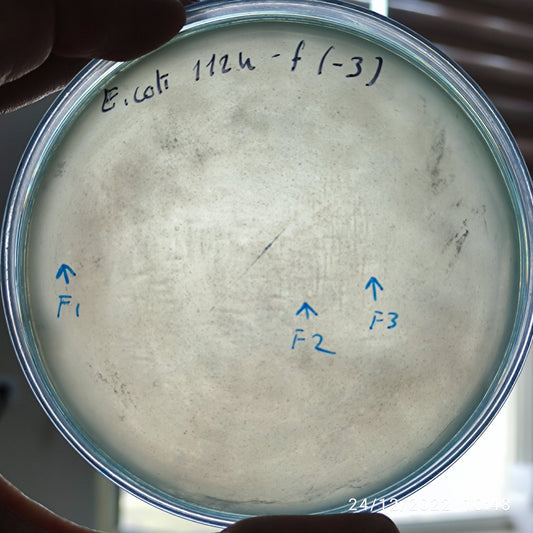
Escherichia coli bacteriophage 101124F
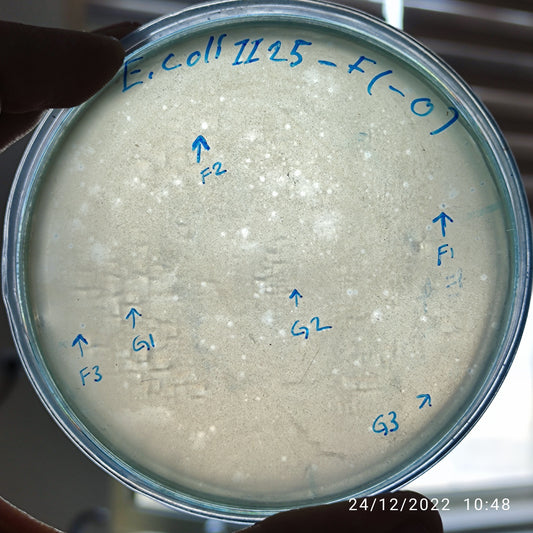
Escherichia coli bacteriophage 101125F
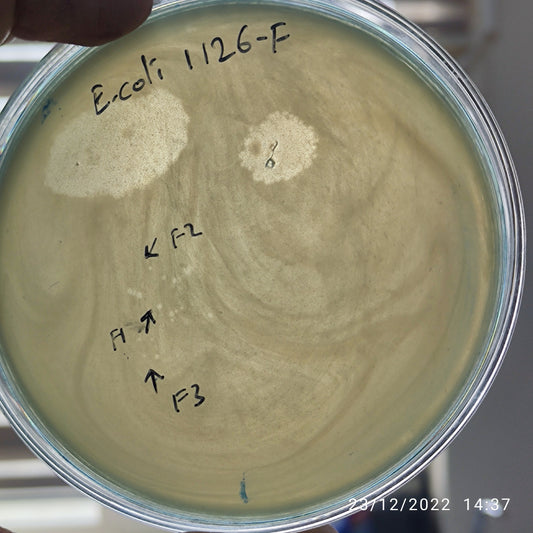
Escherichia coli bacteriophage 101126F
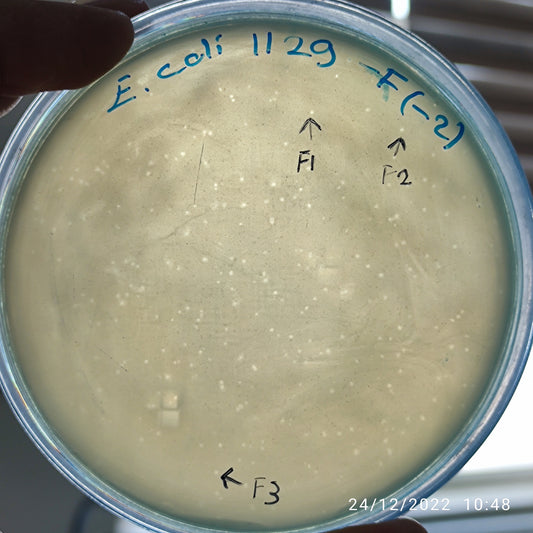
Escherichia coli bacteriophage 101129F
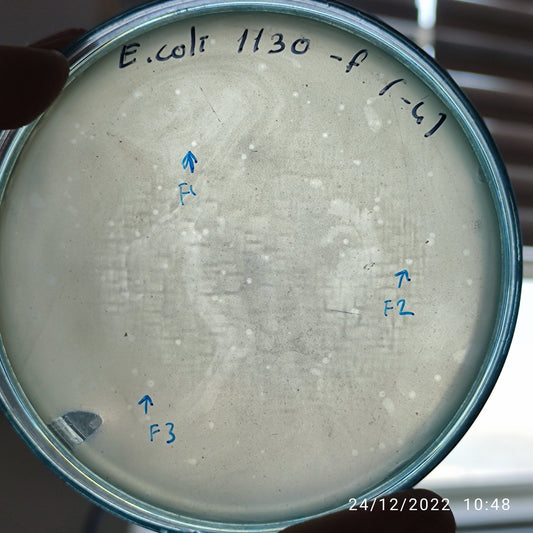
Escherichia coli bacteriophage 101130F

-
Escherichia coli bacteriophage 101118F
Regular price $500.00 USDRegular priceUnit price per -
Escherichia coli bacteriophage 101118G
Regular price $500.00 USDRegular priceUnit price per -
Escherichia coli bacteriophage 101119F
Regular price $500.00 USDRegular priceUnit price per -
Escherichia coli bacteriophage 101120F
Regular price $500.00 USDRegular priceUnit price per -
Escherichia coli bacteriophage 101121F
Regular price $500.00 USDRegular priceUnit price per -
Escherichia coli bacteriophage 101122F
Regular price $500.00 USDRegular priceUnit price per -
Escherichia coli bacteriophage 101122G
Regular price $500.00 USDRegular priceUnit price per -
Escherichia coli bacteriophage 101123F
Regular price $500.00 USDRegular priceUnit price per -
Escherichia coli bacteriophage 101123G
Regular price $500.00 USDRegular priceUnit price per -
Escherichia coli bacteriophage 101124F
Regular price $400.00 USDRegular priceUnit price per -
Escherichia coli bacteriophage 101125F
Regular price $500.00 USDRegular priceUnit price per -
Escherichia coli bacteriophage 101125G
Regular price $500.00 USDRegular priceUnit price per -
Escherichia coli bacteriophage 101126F
Regular price $500.00 USDRegular priceUnit price per -
Escherichia coli bacteriophage 101128F
Regular price $500.00 USDRegular priceUnit price per -
Escherichia coli bacteriophage 101129F
Regular price $500.00 USDRegular priceUnit price per -
Escherichia coli bacteriophage 101130F
Regular price $500.00 USDRegular priceUnit price per